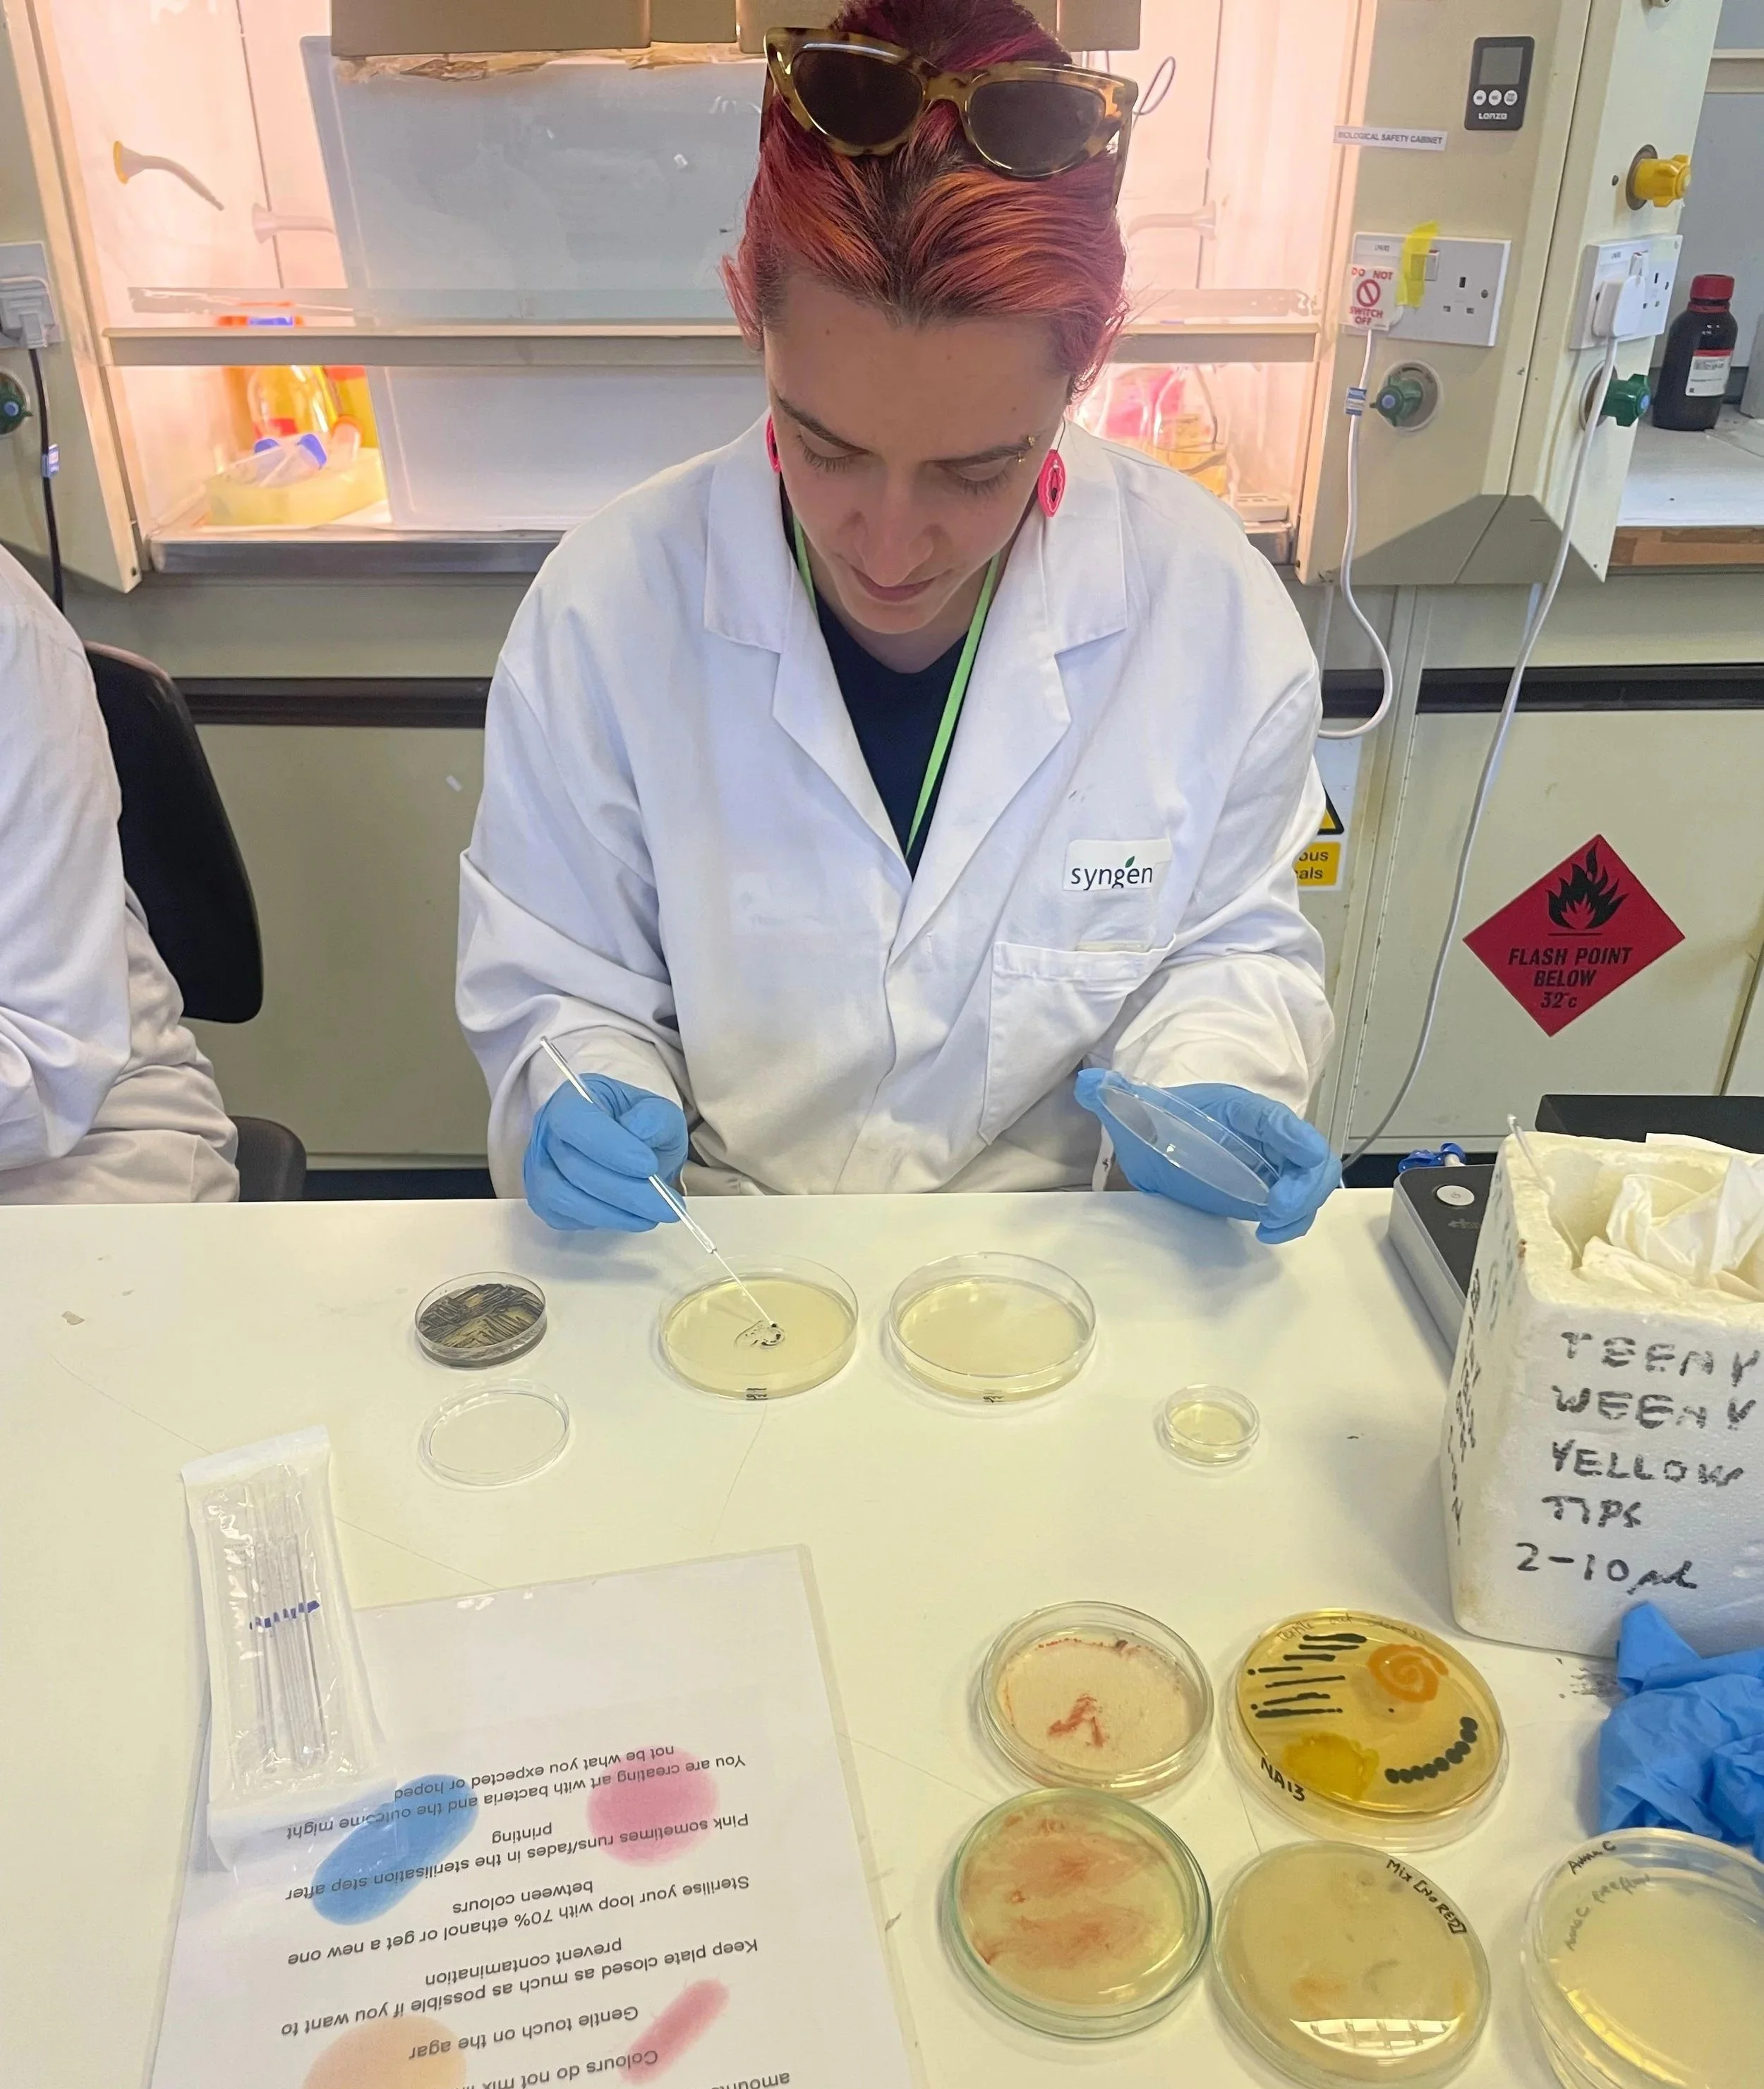

Reflections from the ASCUS Lab
2025 was an incredible year for ASCUS and a year of change. Keeping with that spirit, I usually write posts on behalf of ASCUS, but this year, I’m writing as myself, ASCUS General and Lab Manager.
I’ve been running ASCUS as the only core member of staff since 2022. It’s always felt a bit awkward highlighting achievements and programmes delivered saying “We” when really it's just been “me” and the amount of work involved in delivering these projects and what ASCUS is able to deliver on a shoestring is often overlooked.
The fact that ASCUS could expand the team in 2025 (it’s double the size now) has been revolutionary. As a result (my wonderful colleague encouraged me to make time to apply) ASCUS won the Creative Edinburgh Innovation Award - yes, that’s right - we are an award winning organisation! Sound’s a bit pretentious doesn’t it? Oh well - it’s on our website home page and we will be claiming the tag line from now on, forever and always. But really, it's wonderful that ASCUS has been recognised by Edinburgh’s creative community for what we do.
To prevent turning this update into a full novel, below is a summary of some of the incredible projects ASCUS has been involved with this year, but I strongly encourage you to follow the links for each to get a better idea of the finer details.
Projects
Yes, you read that right. We’re taking colour made by microorganisms out of this world (literally) to see what happens when it encounters cosmic radiation.
We designed a bespoke microscope that lets microscopic pond life call the shots, serving as the ‘brain’ behind audio and visual elements in Rae-Yen Song’s immersive exhibition at Tramway, Glasgow.
After 3 years of collaboration, the outputs of the Surface Echoes project was published. The script and audio version of the resource is found here.
One of the positive outcomes of learning that Summerhall was up for sale was meeting other other Summerhall residents, one of which is art psychotherapist, Alison Wren. After a tour of the lab and getting a sense of what is possible with some of the lab’s microbial friends, Ali and I started brainstorming and the idea for Growing Culture was born.
A partnership between ASCUS and long-term ASCUS Lab users and biotech company, Cexal.
Teaching programmes
Chelsea College of art technician training
Print and dye technicians from Chelsea College of Art joined us for a week for a tailor-made course to learn how to grow microorganisms in the context of art and design and how they might be able to implement some of the techniques in their curriculum.
Edinburgh Montessori Arts School
The last quarter of 2025 was great joy as I got to venture out to the wonderful Edinburgh Montessori Arts school. My mission: Inspire teens about all things science in a hands-on way. We’ve made patterns with bacteria, analysed soil with soil chromatography, made leather with bacteria and yeast, and so much more! I’m really looking forward to carrying on with these sessions in 2026.
Lab users
As always, I am blown away by the ideas and the work that gets developed in the ASCUS Lab. Below are just a few examples of the incredible creatives that I have crossed paths with this year.
Louise Gibson - Experiments on testing bio-resin colours and reclaimed textiles dyed with pigmented bacteria, implemented in sculptures in Beachheads, a summer commission by Edinburgh Sculpture Workshop.
Morag Patterson - Used the lab microscopes to explore the aerobiome and other micro-life in forests
Caitlin Dick - Experimenting with microscopic images of moss in screen printing
Meg Connor-Scahill - Using pigmented bacteria on textiles for her degree show at ECA.
Waad AlBawardi - The lab was transported into a microscopic kaleidoscope of colour and “ooohs” and “aaaahs” with this crystallography workshop.
To keep this momentum going, we need more financial support. Our funding is project based which sometimes limits our ability to think long-term and capacity. Imagine what we could do with consistent core funding! Please consider making a donation or getting in touch if you would like to work with us.
Ok, well that’s a wrap of an incredible year. There are already really exciting things in the pipeline for ASCUS in 2026, especially with the ASCUS Lab’s 10th birthday coming up this year! I very much look forward to sharing what we get up to as the year progresses so stay tuned!
— Keira Tucker, ASCUS General & Lab Manager